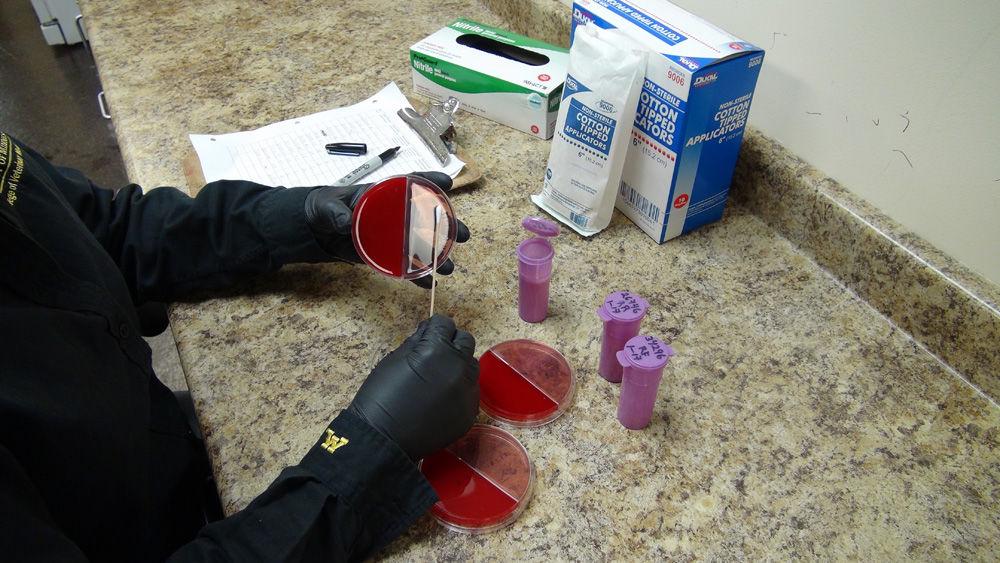

Crop
Sow and Grow with Sara: Unsolicited seed and good grain storage practices
瑞友慧连接:简介 连接一切,局域网应用internet化,让异地访问更便捷,更流畅 应用提速,网络加速,让网络应用访问速度更快捷 私有云构建,助力企业实现应用集中发布,系统统一管理,数据安全储存
安卓 vp n

[分享]实用-ADSL测速、加速、检测故障全解决_家电维修论坛:2021-2-26 · [分享]实用-ADSL测速、加速、检测故障全解决,家电维修论坛家电维修论坛,家电维修技术 家电维修论坛 家电维修文章 热门 最新 精华 网站地图 论坛列表 论坛XML 板块XML

Ag Appreciation lunch is Wednesday

Happy birthday to one of the best

Breeders find new weapon to fight wheat scab

Weekly drought webinars start this week for Iowa producers

State Fair offers grandstand entertainment, tickets on sale now

Two South Dakota fairs symbolize a return to normalcy

Crop Watcher: Crops developing quickly in northeastern South Dakota

cFosSpeed 网络优化加速器 Ping优化器 – 正版软件商城丨 ...:2021-11-19 · cFosSpeed 网络优化加速器 Ping 优化器 618 鼠标悬停放大 点击展开 cFosSpeed 网络优化加速器 Ping优化器 ...

Crop Watcher: Rain fall varies from 1.5 to over 6 inches across Minnesota

COVID changes consumer values around food
安卓 vp n

Your Money
安卓 vp n

Fork on the Prairie Road
Discover Day County’s rock structures

Livestock
Hereford 'family': Junior association promotes Hereford breed

Livestock
Vet Report: Dealing with fly control in pastured cattle
- see all top ads
安卓 vp n
Kibble Equipment Auction

Grand Forks Area Auction

Fox Auction

Cahoon Auction

Trending Now
-
Happy birthday to one of the best
-
华为荣耀路由3评测 Wi-Fi 6+游戏加速 重新定义连接体验_路由 ...:今天 · 除了出色的网络性能外,荣耀路由 3 的功能也很丰富。全新的荣耀路由 3 支持游戏加速、Wi-Fi 密码防暴力破解、网课加速等众多实用功能。其中的网课加速支持 VIPKID、沪江网校、52Talk、学而思网校、钉钉、腾讯会议、企业微信、Welink 等大量网课类与办公
-
Crop Watcher: Preparing for estate sale brings up many memories
-
Two South Dakota fairs symbolize a return to normalcy
-
Crop Watcher: Great community support for new farm stand
Recent E-Edition

e-Edition
Tri-State Neighbor 7-31-2024
News

加速网络连接
Ag Appreciation lunch is Wednesday

State & Regional
Happy birthday to one of the best

State & Regional
Weekly drought webinars start this week for Iowa producers

State & Regional
cFosSpeed 网络优化加速器 Ping优化器 – 正版软件商城丨 ...:2021-11-19 · cFosSpeed 网络优化加速器 Ping 优化器 618 鼠标悬停放大 点击展开 cFosSpeed 网络优化加速器 Ping优化器 ...
网络加速器cFosSpeed正版团购 优惠价仅28元终身授权|蓝点网:网络加速器cFosSpeed正版团购 优惠价仅28元终身授权 山外的鸭子哥 软件工具 2021年4月14日 16:45:32 108 2 ———-本文已在2021年11月4日更新 ...

Livestock
USDA report focuses on improvements for small processors after cattle market investigation

加速网络连接
Livestock water testing available through SDSU

Livestock
Keep an eye out for blue-green algae around livestock

Livestock
Be Prepared: Having a plan before a fence project can spare headaches later
安卓 vp n

Crop
出海业务网络加速方案技术能力详解_qwefgh123321的专栏 ...:2021-6-12 · 点击观看大咖分享随着出海业务的持续发展,各出海业务场景对于网络的要求越来越高。本课程针对出海业务的网络加速方案,进行腾讯云全球应用加速技术能力详解。全剧应用加速依赖全球节点之间的高速通道、转发集群及智能路由技术,实现各地用户的就近接入,通过高速通道直达源站区域 ...

Crop
Chad Harms elected to District 1 Corn Board

Crop
Plan early for propane purchase, experts say

Crop
Farmers use array of strategies for planting cover crops

Crop
Stretching the use of corn

Crop
Iowa farmers encouraged to vote in corn board elections

Crop
Leadership program seeks young farmers
Dairy

Dairy
华为荣耀路由3评测 Wi-Fi 6+游戏加速 重新定义连接体验_路由 ...:今天 · 除了出色的网络性能外,荣耀路由 3 的功能也很丰富。全新的荣耀路由 3 支持游戏加速、Wi-Fi 密码防暴力破解、网课加速等众多实用功能。其中的网课加速支持 VIPKID、沪江网校、52Talk、学而思网校、钉钉、腾讯会议、企业微信、Welink 等大量网课类与办公

加速网络连接
Yesteryear: Milking time

State & Regional
In need of help themselves, dairy farmers also reach out to help others

Dairy
Dairy Expo board elects new executive committee
Dairy
Prevention, judicious treatment key with antibiotic use in dairy

加速网络连接
猎豹加速器,连接你我:猎豹加速器为您的iphone和ipad解锁国内网络限制 猎豹加速器让您在手机上尽情享受国内的网络资源 猎豹加速器让您在PC ... 一点即可连接到。超级简单,好用。 线路加密 你所使用的每一条线路都是加密显示的,所有登录过的网站 ...

Rural Life
Yesteryear: A proper test

Dairy
New dairy podcast tailors information for I-29 corridor
State & Regional

State & Regional
Ag Appreciation lunch is Wednesday

加速网络连接
Happy birthday to one of the best

State & Regional
Weekly drought webinars start this week for Iowa producers

State & Regional
State Fair offers grandstand entertainment, tickets on sale now
Rural Life

Rural Life
Get take-out fair food, help local non-profits

Rural Life
猎豹加速器,连接你我:猎豹加速器为您的iphone和ipad解锁国内网络限制 猎豹加速器让您在手机上尽情享受国内的网络资源 猎豹加速器让您在PC ... 一点即可连接到。超级简单,好用。 线路加密 你所使用的每一条线路都是加密显示的,所有登录过的网站 ...

Rural Life
Yesteryear: Dairy cattle at Little I

Rural Life
Yesteryear: A proper test
加速境外网络的方式有哪些? -「云杰通信」:2021-6-12 · 网络加速 专线特点: 1、 速度快,加速后速度比原来快好多; 2、 安全性好,加速专线采用独享专线出口,安全有保障 ... 如果您的企业需要经常连接 到国外的网站查阅信息,或与国外的合作伙伴联系,如果您在国外设有办事处,是跨地区企业 ...

Your Money
Your Money: You may think you are, but you’re not in the clear
Michael Baron
Columnist

Your Health
Your Money: Overactive thyroid leads to insomnia
Joe and Teresa Graedon
Columnists

加速网络连接
华为余承东发布5G工业模组MH5000 加速全场景连接千行 ...:2021-2-24 · 华为消费者业务CEO余承东在西班牙巴塞罗那举办的终端产品与战略线上发布会,面向全球正式发布了全新升级的全场景智慧生活战略及5G全场景智慧终端旗舰新品,其中华为5G工业模组MH5000是此次发布会唯一面向2B行业的5G产品。
Sheri Poore
Tri-State Neighbor columnist

Pennywise
Pennywise: Tips for cleaning cast iron pans
Paula Vogelgesang
安卓 vp n
安卓 vp n

安卓 vp n

腾讯网游加速器加速失败常见错误码怎么解决_加速失败常见 ...:2021-11-13 · 想必很多玩家在使用加速器的时候多少会遇到一些错误码,那么该怎么解决呢?下面小编就来给大家详细介绍一下,感兴趣的玩家一起来看看吧! 腾讯网游加速器加速失败常见错误码及解决办法

China’s Q1 demand for pork strong: NPPC

Coronavirus creates uncertainty about trade deal

Oil’s crash reminds farmers they’re also energy traders
安卓 vp n
CRARY INDUSTRIES INC - Ad from 2024-07-17

Deerfield Truck & Equipment - Ad from 2024-07-17

RIVERSIDE HOOP BARNS - Ad from 2024-07-17

SIOUX FALLS CHAMBER OF COMMERCE - Ad from 2024-07-17

加速网络连接

SUMMERS MFG - Ad from 2024-07-31

Piroutek Auction Service - Ad from 2024-07-31

JOHNSON & SONS CONST - Ad from 2024-07-17
